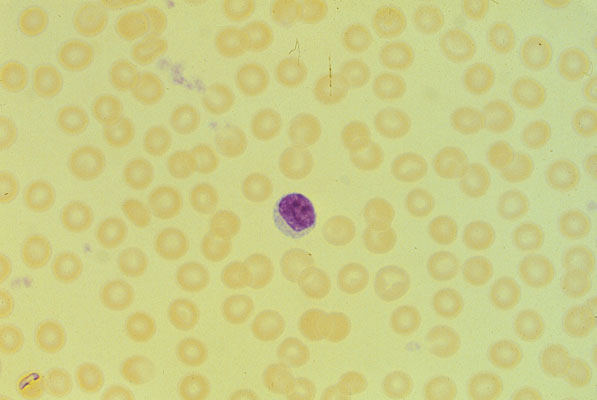

Pancytopenia in aplastic anemia, peripheral blood
Click picture to enlarge. Close window to return
In aplastic anemia, there is usually a decrease in RBCs, WBCs and platelets. The anemia is usually normochromic and normocytic, and the reticulocyte count is low. There are few platelets in this field, and only one WBC.